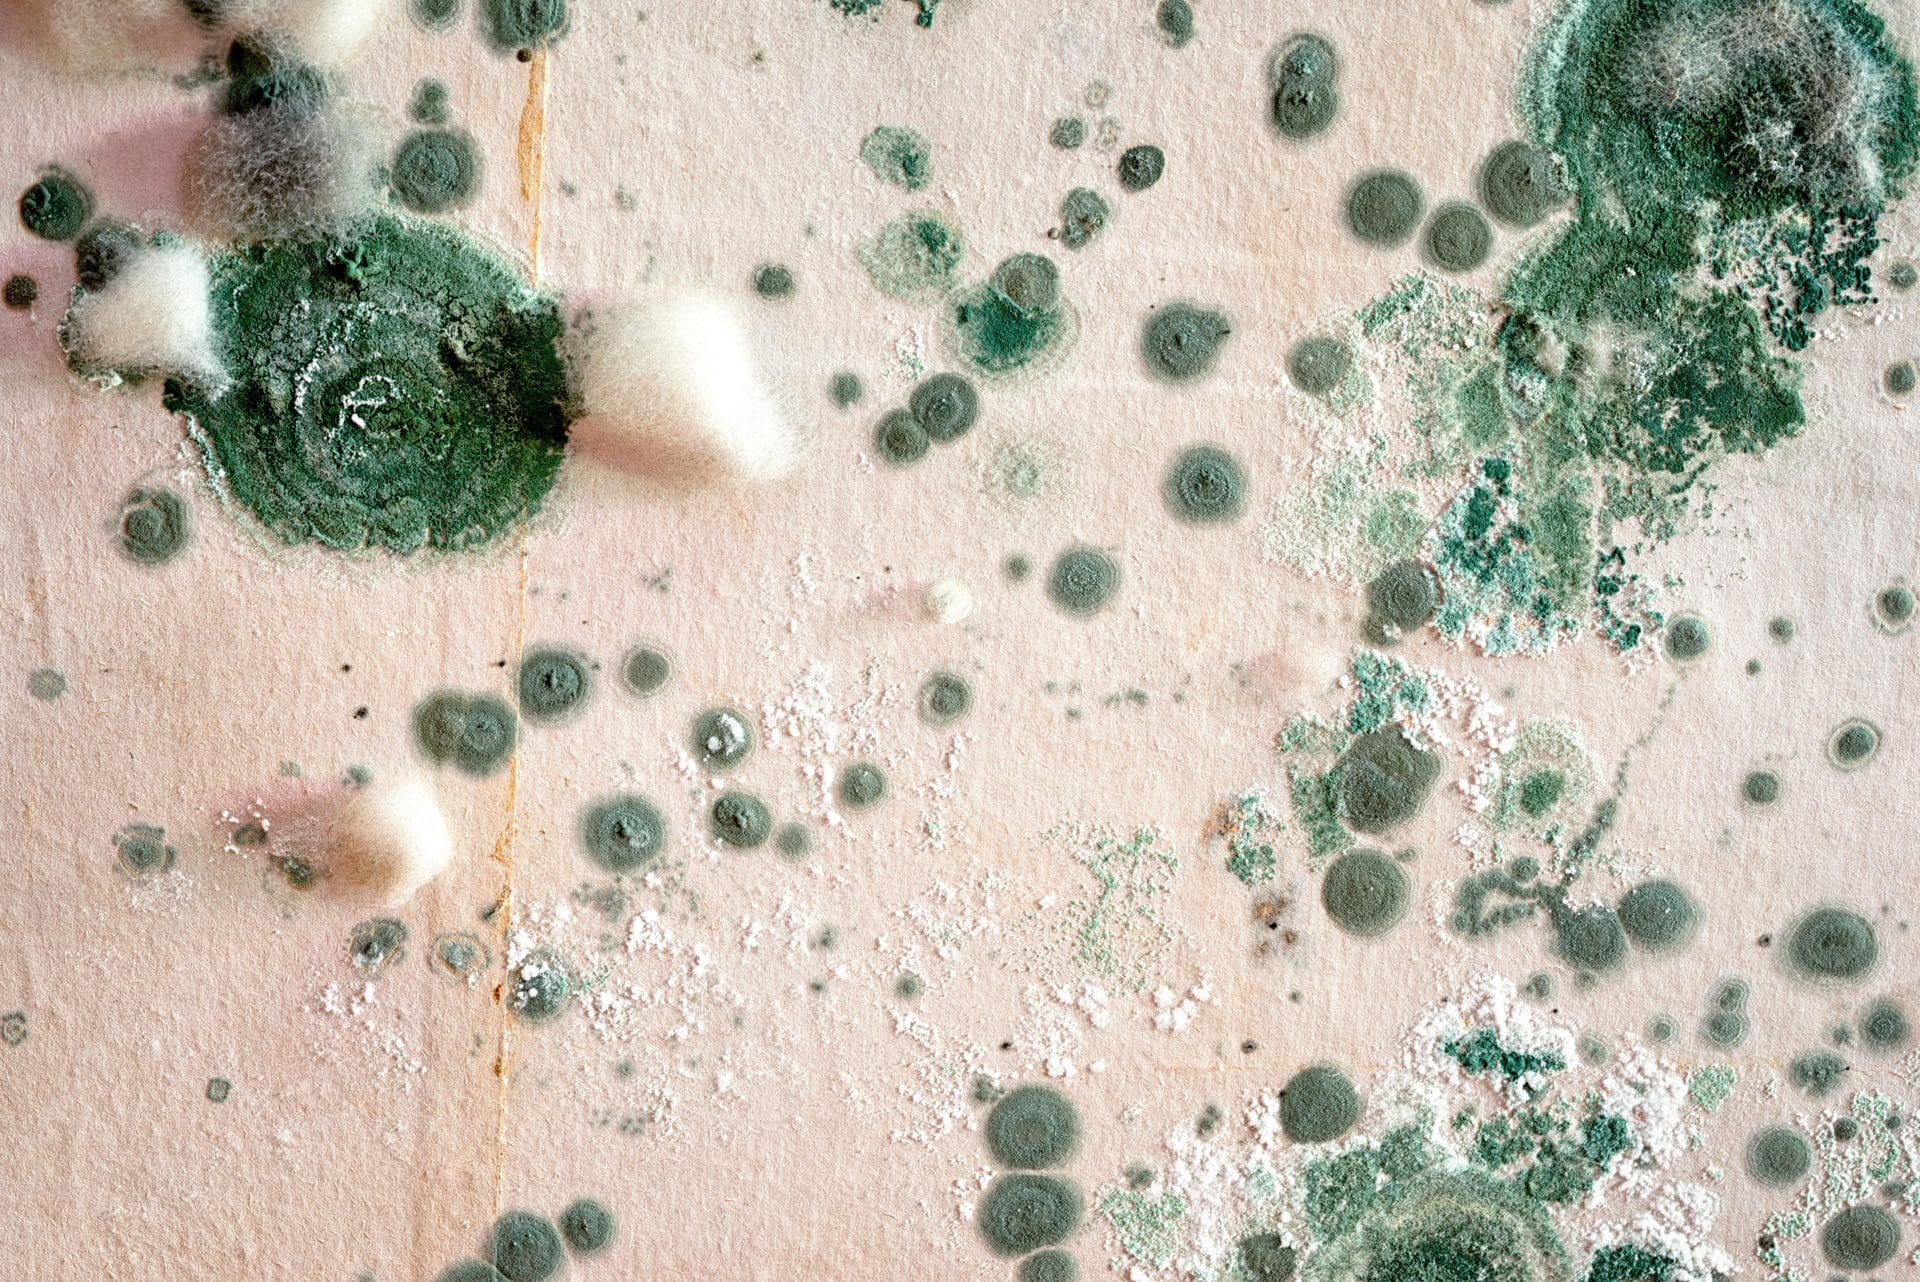
Grüner Schimmel (© elen31 / stock.adobe.com)

Schimmelarten im Wohnumfeld: Welche Schimmelpilze sind gefährlich, und wie werde ich sie wieder los?
Die wenigsten Menschen wissen, wie viele Schimmelarten es weltweit tatsächlich gibt: Grob geschätzt sind es mehr als 250.000, wovon bisher allerdings erst rund 100.000 Arten bestimmt worden sind. Doch nur wenige davon sind in Häusern und Wohnungen vorhanden und können zu Schäden am Gebäude sowie zu gesundheitlichen Beschwerden führen (Aspergillus, Aspergillose). Besonders oft treten in Wohnräumen der schwarze Schimmel, der weiße Schimmel und der grüne Schimmel auf. Doch auch roter und gelber Schimmel sind keine Seltenheit.
Einen optimalen Nährboden für die Entwicklung von Schimmelpilzen bietet bekanntlich Feuchtigkeit – so können sich mit der Zeit beachtliche Pilzkolonien entwickeln. Dabei bestimmt insbesondere der Fruchtkörper des Schimmelpilzes seine Färbung. Um die verschiedenen Schimmelpilzarten eindeutig zu bestimmen, muss auf deren Struktur und Farbe geachtet werden.

Die häufigsten Schimmelpilzarten in Haus und Wohnung
► Schwarzschimmel
Schwarzer Schimmel kommt hierzulande in rund 40 unterschiedlichen Arten vor und zeigt sich in Wohnhäusern vor allem in Ecken (Warum bildet sich Schimmel in den Ecken?) oder auf Tapeten. Für ein optimales Wachstum ist er auf ein feuchtwarmes Umfeld angewiesen. Aus diesem Grund lässt sich schwarzer Schimmel relativ oft im Badezimmer entdecken (vgl. Schimmel im Bad), wie zum Beispiel in der Nähe des Fensters sowie auch an anderen Orten mit hoher Luftfeuchtigkeit. Das können Rückwände von Schränken, Mauern oder Silikonfugen von Fliesen sein (vgl. Wasserschaden hinter Fliesen).
Schwarzer Schimmel kann sämtliche organischen Stoffe und sogar Metall oder Glas angreifen. Schwarzschimmel kommt auf der ganzen Welt vor und lässt sich weder von Lauge noch von Säure in seinem Wachstum beeinflussen, zudem kann er auch starken Temperaturschwankungen standhalten. Er entwickelt sich bereits ab einer Temperatur von 6 °C und kann bis zu 45 °C gut gedeihen. Deshalb zeigt sich der Schimmel häufig in Garagen, Kellern oder auch Dachböden – also tendenziell eher dort, wo es kühler ist.
Für die Gesundheit besteht insbesondere eine Gefahr durch die Aufnahme über Lebensmittel. Doch auch Menschen mit einem weniger starken Immunsystem sowie auch Allergiker können durch Sporen des Pilzes erkranken. Klassische Symptome sind Beschwerden der Atemwege, allergische Reaktionen oder auch gerötete Augen.

► Roter Schimmel
Rotschimmel lässt sich insbesondere auf Getreide sowie auch auf Erzeugnisse aus Getreide nieder. Er wird auch als Roter Bäckerschimmel bezeichnet, was den Grund hat, dass insbesondere Bäcker aufgrund des Pilzes öfter unter Atemwegserkrankungen leiden. Vom Rotschimmel betroffene Lebensmittel weisen für gewöhnlich einen hohen Anteil an Zucker, Stärke und Kohlenhydrate auf – die wichtigsten Stoffe, von denen sich der Rotschimmel ernährt. Weil auch Zellulose zu seinen bevorzugten «Nährstoffen» gehört, sind auch Papier und Holz öfter von rotem Schimmel befallen.

► Grüner Schimmel
Grüner Schimmel breitet sich auf allen Arten von Lebensmitteln auf und stellt aufgrund seiner Freisetzung von Schimmelpilzgiften auch eine gewisse Gesundheitsgefahr für den Menschen dar. Auch auf feuchten Decken und Wänden können die Sporen einen idealen Nährboden finden, um weiter zu wachsen. Vor allem feuchte Bereiche im Haus, wie Küche und Badezimmer sowie generell schlechter belüftete Bereiche sind mitunter davon betroffen.
Nicht zu unterschätzen ist das gesundheitliche Risiko für den Menschen: Die Sporen von Grünschimmel können eine starke allergische Wirkung auf den Menschen haben und somit unter anderem zu Reizungen der Schleimhäute, Müdigkeit, Migräneerscheinungen oder Erkrankungen der Atemwege führen. Ebenfalls gedeiht diese Schimmelart auf Zimmerpflanzen- und Blumenerde, die sich in der Nähe von Heizkörpern befindet.
► Gelber Schimmel
Gelbschimmel zählt zu den gefährlichsten Arten von Schimmelpilzen, sie kommen allerdings eher in Bereichen mit schlechten Hygienestandards vor und sind daher in Wohnräumen hierzulande eher eine absolute Ausnahme. Gelber Schimmel gedeiht vor allem auf Polstermöbeln und Baumwollstoffen. Er zeigt sich als bräunlich-gelber Belag mit schmieriger oder auch trockener Oberfläche. Genau wie auch schwarzer Schimmel stellt Gelbschimmel eine nicht zu unterschätzende Gefahr für unsere Gesundheit dar. In ihm enthalten ist das Stoffwechselgift Aflatoxin, welches in Verdacht steht, Erkrankungen wie Leberkrebs oder gar Herzversagen zu fördern.

► Weißer Schimmel
Weißer Schimmel zeigt sich insbesondere in Ecken von Fußböden und Decken, hinter Möbeln an Außenwänden oder auch in feuchten und kühlen Räumen. Im Gegensatz zu anderen Schimmelpilzarten handelt es sich bei Weißschimmel um eine eher «dezente» Art / Gattung des Pilzes, was ihn allerdings nicht weniger gesundheitsgefährdend macht. Erkennen lässt sich weißer Schimmel an einem modrigen, unangenehmen Geruch (Schimmelgeruch, vgl. auch: weißer Schimmel im Keller) sowie auch an vermehrt auftretendem Ungeziefer wie Kellerasseln oder auch Silberfischchen. Weil weißer Schimmel unsere Schleimhäute reizen kann, zeigen sich als Folge mitunter Erkrankungen wie Erkältungen, Hautprobleme, Bronchitis oder auch Nasennebenhöhlenentzündungen.

So lässt sich in Wohnräumen die Schimmelgefahr bewerten
Schimmel ist keinesfalls ein Zeichen von mangelnder Hygiene, sondern kann auch durch ganz alltägliche Fehler entstehen. Falsches Lüften oder Heizen, schlecht platzierte Möbel, dazu noch die richtige Temperatur und der nötige Grad der Feuchtigkeit – schon hat Schimmel in der Wohnung leichtes Spiel und kann sich schnell entwickeln.
Mangelhaftes oder falsches Lüften und Heizen zählt zu den häufigsten Gründen für die Entwicklung von Schimmelpilzen in Wohnräumen. Wer oft genug und richtig lüftet, sorgt dafür, dass die Luftfeuchtigkeit im Raum entweichen und ein angenehmes Raumklima geschaffen werden kann. Aus diesem Grund sollten Fenster möglichst nicht in Kippstellung verbleiben – besser ist es, mehrfach täglich Fenster und Türen vollständig zu öffnen, damit ein vollständiger Luftaustausch erfolgen kann.
Wenn sich an Fenstern und Fensterbänken öfter Kondenswasser bildet, ist dies ein klassisches Indiz für einen zu hohen Temperaturunterschied zwischen dem Innen- und Außenbereich. Insbesondere an Dachfenstern kommt es durch die Schräglage öfter zur Auskühlung von Fenstern – hier ist Kondenswasser typisch. Dies ist zwar zunächst nicht schädlich, kann jedoch mit der Zeit zur Entwicklung diverser Schimmelpilzarten führen.


Auch eine falsche Platzierung von Möbeln fördert die Entwicklung von Schimmel: Stellt man große Möbel, wie Schränke oder Kommoden, zu dicht an Außenwände, so kann die Luft dahinter nicht richtig zirkulieren und das Schimmelrisiko steigt drastisch.
Der wichtigste Nährboden für Schimmel ist allerdings die Feuchtigkeit. Je höher diese in Wohnräumen ist, desto größer ist auch die Wahrscheinlichkeit von Schimmel in der Dusche oder an anderen Stellen im Haus. Problematisch wird es ab einem Wert von 70 %. Deshalb empfehlen wir eine Feuchtigkeitsmessung mithilfe eines Hygrometers, um jederzeit entsprechend reagieren zu können.
Diese Anzeichen weisen auf Schimmelpilze in der Wohnung hin
Es gibt einige klassische Anzeichen, die ein Hinweis auf einen Befall mit Schimmel sein können: Riecht es in den Wohnräumen modrig und unangenehm, auch wenn mehrfach täglich gelüftet wird, so kann dies auf diverse Schimmelarten hindeuten. Schwarze Flecken oder Pünktchen an den Wänden zeigen sich vor allem in Ecken, aber auch an Fensterbänken, auf Silikonfugen oder hinter größeren Möbelstücken. Ist der Befall bereits fortgeschritten, so zeigen sich häufig gesundheitliche Beschwerden oder sogar Allergien bei den Bewohnern.
Eine eindeutige Antwort kann hier ein Schimmelexperte geben, falls man das Problem selbst nicht finden kann – er entnimmt Proben und untersucht diese sehr genau.

Schimmelpilzsanierung – so lässt sich Schimmel auf unterschiedliche Arten wirksam beseitigen
Wenn feststeht, dass ein Schimmelbefall in der Wohnung vorliegt, so sollte dieser so schnell wie möglich beseitigt werden. Wie genau die Schimmelbeseitigung ablaufen sollte, hängt vor allem davon ab, wie stark der entsprechende Bereich vom Pilz befallen ist.
Oberflächlicher Pilzbefall, wie beispielsweise auf lackierten Hölzern, Metall oder auch Keramik lässt sich für gewöhnlich ganz einfach mit einem feuchten Tuch und Haushaltsreiniger und anschließend mit Ethylalkohol abwischen. Reiben Sie die Stelle danach unbedingt gründlich trocken. Dies funktioniert bei den meisten Schimmelarten.
Kleinere (!) Flecken an den Wänden von Arten wie Schwarzschimmel oder weißem Schimmel lassen sich normalerweise gut mit Hausmitteln bekämpfen, allerdings sollte nie ausgeschlossen werden, dass sich hinter dem Schimmelfleck ein noch größerer Befall befindet. Daher ist anzuraten, die entsprechende Stelle genauer zu beobachten: Tritt der Schimmel nach dem Entfernen erneut auf, kann es sich durchaus um einen versteckten Wasserschaden in der Wand handeln.
Grundsätzlich gilt: Ab einer Fläche von mehr als 50 cm sollten Sie die Beseitigung einem Fachmann zeigen: Ein Sachverständiger für Schimmel (vgl. auch Welcher Handwerker bei Schimmel?) kann sich die Situation vor Ort erst einmal genau ansehen, die Schimmelpilzarten feststellen und im Anschluss die richtigen Maßnahmen empfehlen, um das Problem dauerhaft zu lösen.
Gern vermitteln wir Ihnen die richtigen Experten aus dem Netzwerk der Deutschen Schadenshilfe. Nehmen Sie noch heute Kontakt mit uns auf!





